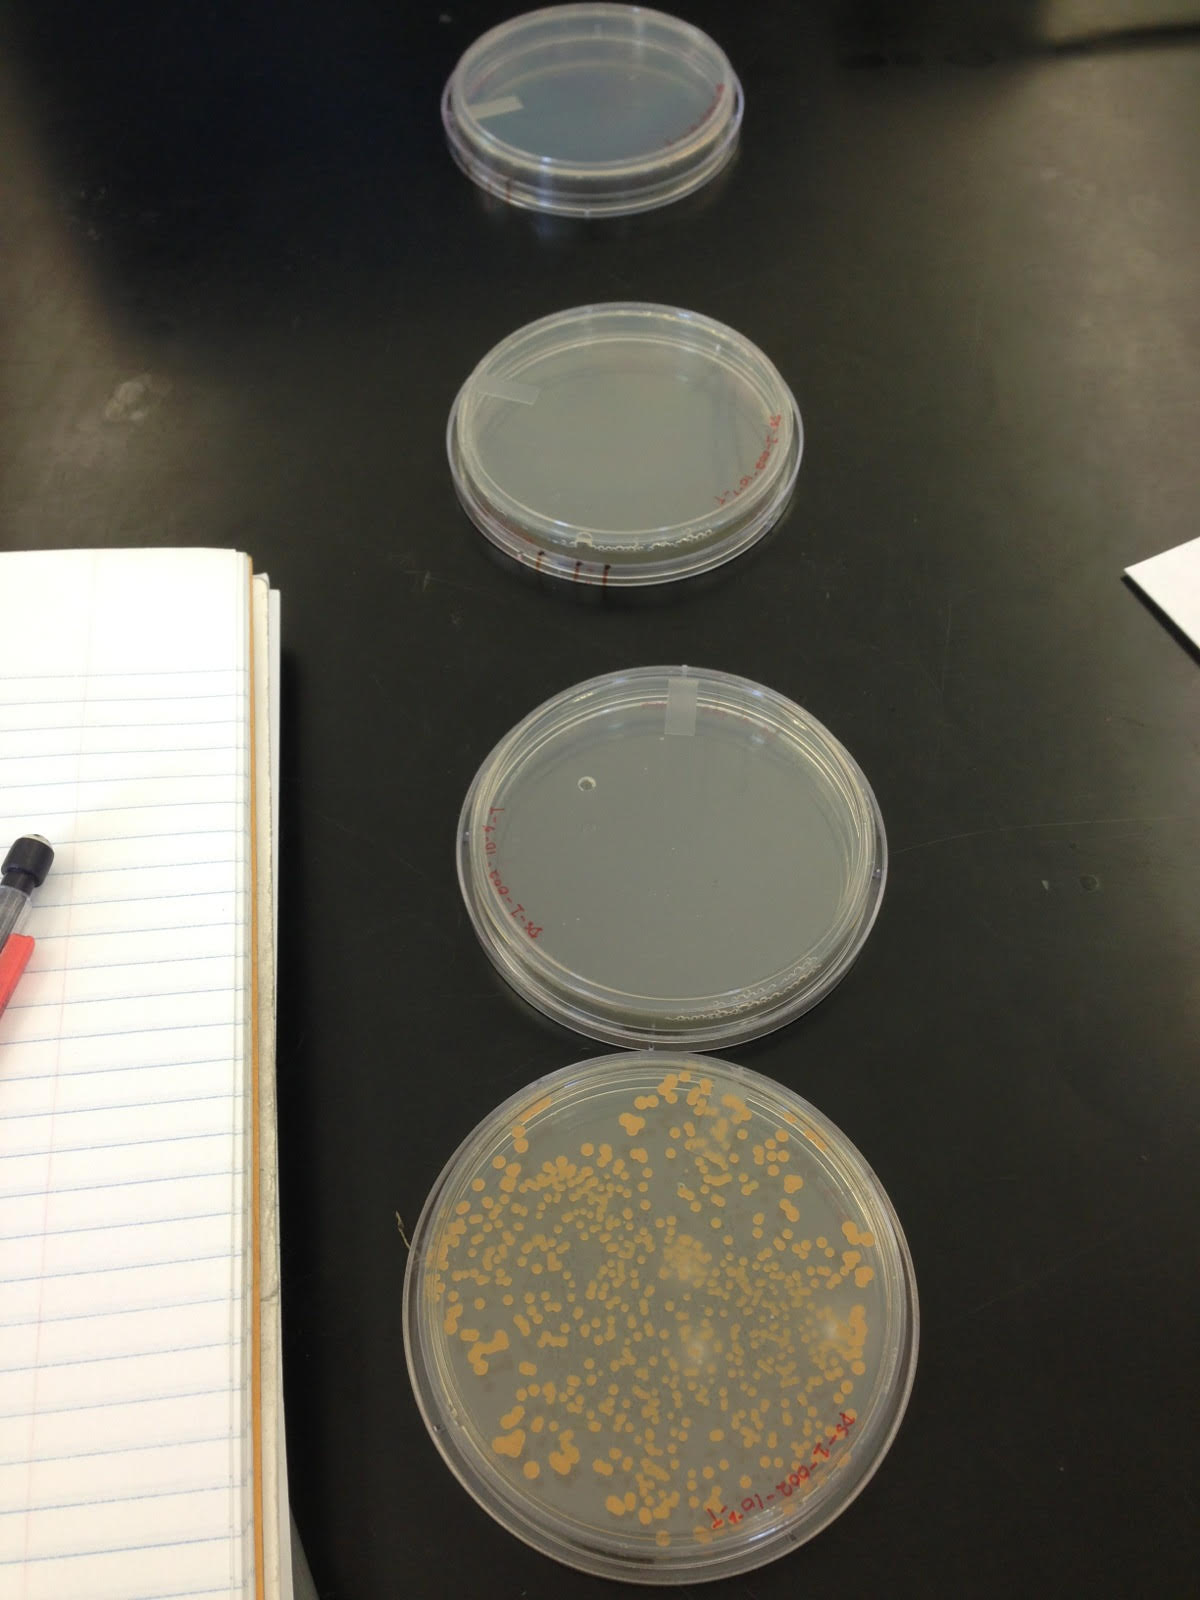

User:Safaan Syed/Notebook/Biology 210 at AU
Lab 5: Invertebrate Identification
Purpose: Identify and classify invertebrates found in the transect environment.
Method: A leaf litter was collected from the transect and then placed in a funnel. The funnel was then attached to a tube containing 25mL of a 50:50 ethanol/water solution using parafilm and tape. The Burlese funnel was then treated with a heat source from above which led the invertebrates in the litter to flee into the solution where they were then trapped.
Data & Observations:
Invertebrate 1:
Size: 50 µm
Number in sample: 15
Phylum: Arthropoda
Class: Arachnida
Order: Acarini
This organism was classified as a Mighty Mite by the dichotomous key.
Invertebrate 2:
Size: 550 µm
Number in sample: 1
Phylum: Arthropoda
Class: Insecta
Order: Siphonoptera
The dichotomous key indicated that this to be a flea.
Invertebrate 3:
Size: 250 µm
Number in sample: 1
Phylum: Arthropoda
Class: Insecta
Order: Hymenocta
The dichotomous key indicated this to be a kind of wasp.
Invertebrate 4:
Size: 57.5 µm
Number in sample: 4
Phylum: Arthropoda
Class: Insecta
Order: Collembola
The invertebrate discussed is just above invertebrate 3
Invertebrate 5:
Size: 325 µm
Number in sample: 1
Phylum: Arthropoda
Class: Insecta
Order: Collemba
The dichotomous key identified this as a Striped-Spring Tail.
Lab 4: Plant Identification
Purpose: Analyze and classify plants in our transect.
Method: Plant samples were obtained from the transect and cross-sections were analyzed under a microscope.
Data & Observations:
Plant 1

Plant sample was roughly 30cm and in northwestern region. There was a spiral vascularization as seen in the cross-section which would indicate that this plant is a dicot.
Plant 2

Plant sample was roughly 25cm and found toward the eastern side of the transect. Given the lack of circular vascular bundles we can conclude this is a monocot
Plant 3

Plant sample was roughly 30cm and found in the middle of the transect. Note that there seems to be no pattern to the vascular bundle placement and so we can conclude this is a monocot
Plant 4

Plant sample was roughly 26cm and found in the middle of the transect. Given the lack of pattern in the placement of the vascular bundles we can conclude this is a monocot
Lichen 5
This sample is a lichen that was found growing on a broken branch in the center of the transect.
Lab 1: Transect
Purpose: To explore the transect environment and catalog biotic and abiotic components. Samples were collected for a future hay infusion.
Method: The method for this lab was rather straightforward, we simply went out and observed the environment of the transect recoding as we went along.
Data & Observations: Biotic: Trees, Plants, Weeds, Grass, Acorns, Roots, Berries, Animals within soil
Abiotic: Soil, Sprinklers, Lamp Post, Rocks, Edge of Ward Building, Metal Disc
General Observations: Area covered with intermittent patches of grass and weeds. There are small dead plants and bushes which have dried out. There are many small thin trees around the transect and sprinklers sticking out of the ground in various places. There is one larger tree to the right side of the region and underneath it a metal disc was found. There is a lamp post looming over the center of the region. Rocks and acorns are strewn around.
Lab 2: Protists and Algae
Purpose: To identify protists found in the transect environment
Method: A Hay infusion was created by mixing environmental samples with 500mL water and 0.1g dried milk powder. These were allowed to sit for a week before samples were taken from two parts of the hay infusion. These samples were then observed under a microscope and the protists found therein were identified using a dichotomous key.
Data & Observations: Initial description-The hay infusion had a rancid smell and the initial sample had separated into two parts. One of these floated to the top of the water line while the other had settled on the bottom of the jar. An emulsive layer had formed on top of the mixture and mold was growing on one side of the jar.
The two samples taken were both from the top layer. One was taken from the moldy area while the other from the opposite end of the jar.
Protists found: Niche 1 -Colpidium, a very small clear organism that moves around quickly with cilia -Volvox, the final formation of the volvicine line -Gonium, the intermediate form of the volvocine line
Niche 2 -Paramecium, a very large, clear unicellular organism -Chilomonas, a small, clear organism very similar in appearance to colpidium
Lab 3: Gram Staining
Purpose: To find and classify bacteria in the hay infusion sample.
Method: Samples were taken from the hay and serially diluted. Each of these dilutions were then spread in agar plates with and without tetracycline and allowed to grow over a week. Then data was taken about colony growth in each plate and then a gram staining was done on the two best plates from both the tetracycline and non tetracycline categories. These slides were then observed under a microscope with the data recorded. Finally, samples from the respective agar plates were used for PCR analysis. Gram Staining Procedure: 1. Scrape some of the bacterial growth with a loop and smear onto slide 2. Pass through flame with bacterial side up three times 3. Cover with crystal violet for one minute and rinse 4. Cover with Gram's iodine mordant for one minute and rinse 5. Flood with 95% alcohol for 10-20 seconds and rinse 6. Cover with safranin for 20-30 seconds and rinse 7. Blot excess and air dry
Data & Observations:
 Figure 1: Cultures not treated with Tetracycline
Figure 1: Cultures not treated with Tetracycline
Figure 2: Cultures treated with Tetracycline
Figure 2: Cultures treated with Tetracycline
Tet vs. Non-Tet / Dilution / Colony # : Non Tetracycline / 10^-3 / roughly 800, NT / 10^-5 / roughly 130, NT / 10^-7 / 6, NT / 10^-9 / 0, Tetracycline / 10^-3 / roughly 200, T / 10^-5 / 0, T / 10^-7 / 0, T / 10^-9 / 0,
4 samples-
NT~10^-7(foggy), NT~10^-7(orange), T~10^-3(mold), and T~10^-3(no mold)
Details: NT~10^-7(foggy)-bacilli and coccus, all cilia, almost everything is gram negative, NT~10^-7(orange)-bacilli and more coccus, all cilia, rods are gram negative spheres are gram positive, T~10^-3(mold)-bacilli and even more coccus, all cilia, rods are gram negative spheres are gram positive, T~10^-3(no mold)-bacilli, coccus and possibly spirals with additional large mold organisms, all cilia,










